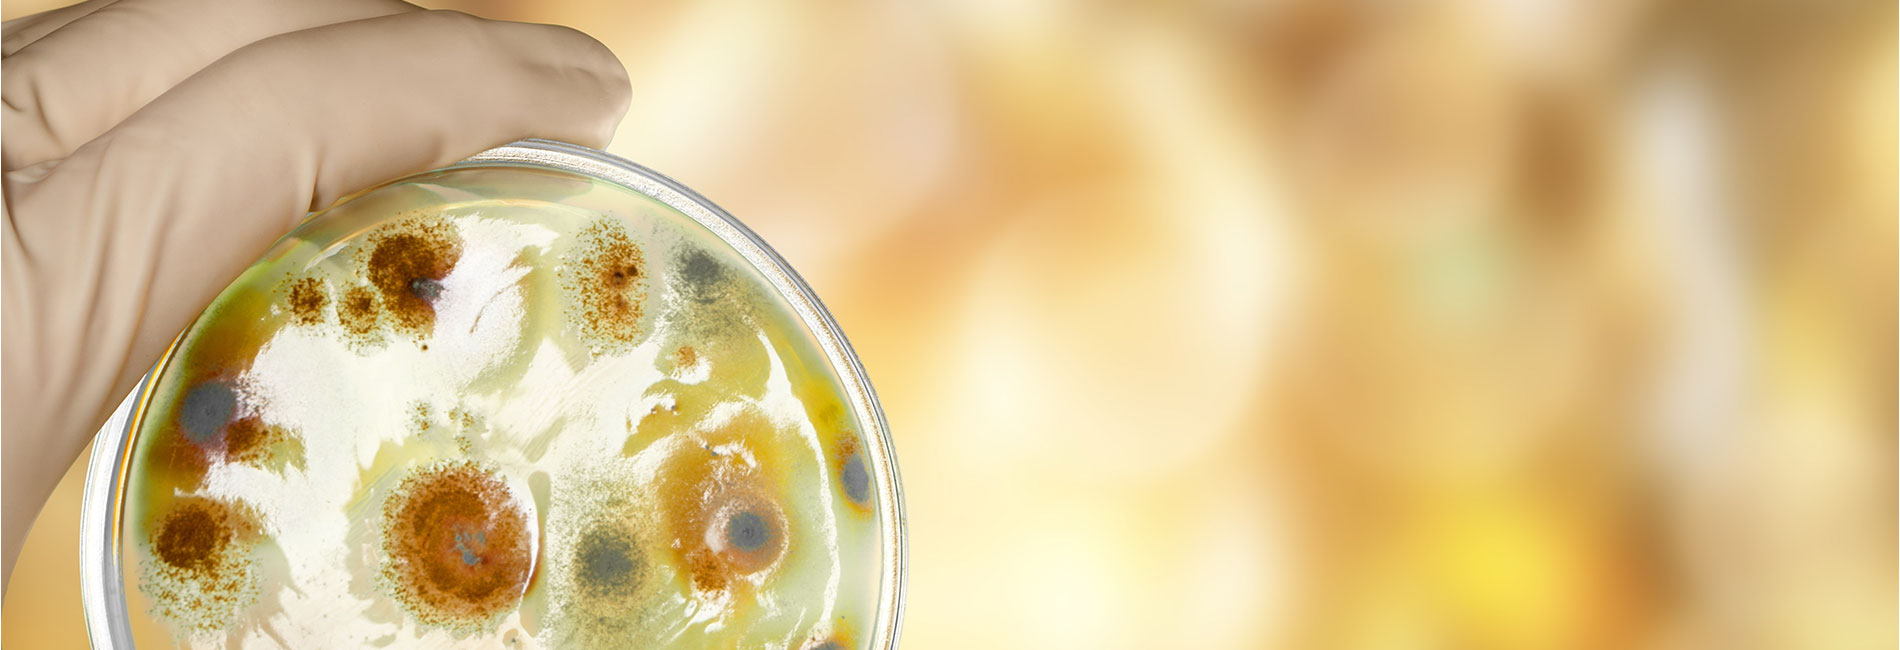

Unsere Leistungen bieten Ihnen umfassende Unterstützung bei der Bewertung von Brandschäden. Wir analysieren Gerüche und beurteilen potenzielle Gefährdungen, um Ihnen Sicherheit zu garantieren. Sollten Sie eine Schimmelpilzanalyse benötigen, stehen wir Ihnen ebenso zur Seite wie bei Feuchtigkeitsmessungen an Baustoffen.
Wir verfügen über das nötige Fachwissen und die modernste Technik, um präzise Diagnosen zu stellen und geeignete Lösungen zu finden.
INGENIEUR- UND SACHVERSTÄNDIGENBÜRO RIECK
Ihr Gutachter für Feuchte-, Brand- und Schimmelpilzschäden, Bauwerksdiagnostik von Gebäuden
in Cottbus / Brandenburg / Berlin / Deutschland
![]() Von der Brandenburgischen Ingenieurkammer (BBIK) öffentlich bestellter und vereidigter Sachverständiger für Schimmelpilze in Innenräumen
Von der Brandenburgischen Ingenieurkammer (BBIK) öffentlich bestellter und vereidigter Sachverständiger für Schimmelpilze in Innenräumen
Adresse
Ingenieur- und Sachverständigenbüro Rieck
Heinrich-Albrecht Str. 16
03042 Cottbus
0355 - 86 92 365
info@ib-rieck
Öffnungszeiten:
Montag - Donnerstag
08.15 Uhr - 13.00 Uhr
14.00 Uhr - 16.30 Uhr
Freitag
8.15 Uhr - 14.30 Uhr
Samstag und Sonntag
geschlossen
sowie nach Vereinbarung